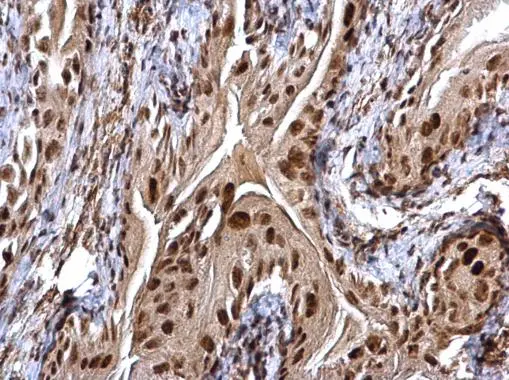
CHD4 antibody detects CHD4 protein at cytosol and nucleus on mouse urinary bladder by immunohistochemical analysis. Sample: Paraffin-embedded mouse urinary bladder. CHD4 antibody (GTX124186) dilution: 1:500. 
 Antigen Retrieval: Trilogy? (EDTA based, pH 8.0) buffer, 15min

Sample (30 μg of whole cell lysate) A: 293T B: A431 C: HeLa D: HepG2 5% SDS PAGE GTX124186 diluted at 1:1000 The HRP-conjugated anti-rabbit IgG antibody (GTX213110-01) was used to detect the primary antibody.
CHD4 antibody
GTX124186
ApplicationsImmunoFluorescence, ImmunoPrecipitation, Western Blot, ImmunoCytoChemistry, ImmunoHistoChemistry, ImmunoHistoChemistry Paraffin
Product group Antibodies
ReactivityHuman, Mouse
TargetCHD4
Overview
- SupplierGeneTex
- Product NameCHD4 antibody
- Delivery Days Customer9
- Application Supplier NoteWB: 1:500-1:3000. ICC/IF: 1:100-1:1000. IHC-P: 1:100-1:1000. IP: 1:100-1:500. *Optimal dilutions/concentrations should be determined by the researcher.Not tested in other applications.
- ApplicationsImmunoFluorescence, ImmunoPrecipitation, Western Blot, ImmunoCytoChemistry, ImmunoHistoChemistry, ImmunoHistoChemistry Paraffin
- CertificationResearch Use Only
- ClonalityPolyclonal
- Concentration1 mg/ml
- ConjugateUnconjugated
- Gene ID1108
- Target nameCHD4
- Target descriptionchromodomain helicase DNA binding protein 4
- Target synonymsCHD-4, Mi-2b, Mi2-BETA, SIHIWES, chromodomain-helicase-DNA-binding protein 4, ATP-dependent helicase CHD4, Mi-2 autoantigen 218 kDa protein
- HostRabbit
- IsotypeIgG
- Protein IDQ14839
- Protein NameChromodomain-helicase-DNA-binding protein 4
- Scientific DescriptionThe product of this gene belongs to the SNF2/RAD54 helicase family. It represents the main component of the nucleosome remodeling and deacetylase complex and plays an important role in epigenetic transcriptional repression. Patients with dermatomyositis develop antibodies against this protein. [provided by RefSeq]
- ReactivityHuman, Mouse
- Storage Instruction-20°C or -80°C,2°C to 8°C
- UNSPSC12352203
References
- Chang CL, Huang CR, Chang SJ, et al. CHD4 as an important mediator in regulating the malignant behaviors of colorectal cancer. Int J Biol Sci. 2021,17(7):1660-1670. doi: 10.7150/ijbs.56976Read this paper
- Ou-Yang F, Pan MR, Chang SJ, et al. Identification of CHD4-β1 integrin axis as a prognostic marker in triple-negative breast cancer using next-generation sequencing and bioinformatics. Life Sci. 2019,238:116963. doi: 10.1016/j.lfs.2019.116963Read this paper
- Wang HC, Chou CL, Yang CC, et al. Over-Expression of CHD4 Is an Independent Biomarker of Poor Prognosis in Patients with Rectal Cancers Receiving Concurrent Chemoradiotherapy. Int J Mol Sci. 2019,20(17). doi: 10.3390/ijms20174087Read this paper
- Luo CW, Wu CC, Chang SJ, et al. CHD4-mediated loss of E-cadherin determines metastatic ability in triple-negative breast cancer cells. Exp Cell Res. 2018,363(1):65-72. doi: 10.1016/j.yexcr.2017.12.032Read this paper
- Hou MF, Luo CW, Chang TM, et al. The NuRD complex-mediated p21 suppression facilitates chemoresistance in BRCA-proficient breast cancer. Exp Cell Res. 2017,359(2):458-465. doi: 10.1016/j.yexcr.2017.08.029Read this paper
- Yeo AJ, Becherel OJ, Luff JE, et al. Senataxin controls meiotic silencing through ATR activation and chromatin remodeling. Cell Discov. 2015,1:15025. doi: 10.1038/celldisc.2015.25Read this paper

![CHD4 antibody detects CHD4 protein at nucleus by immunofluorescent analysis. Sample: HeLa cells were fixed in 4% paraformaldehyde at RT for 15 min. Green: CHD4 stained by CHD4 antibody (GTX101662) diluted at 1:500. Red: alpha Tubulin, a cytoskeleton marker, stained by alpha Tubulin antibody [GT114] (GTX628802) diluted at 1:1000. Blue: Fluoroshield with DAPI (GTX30920).](https://www.genetex.com/upload/website/prouct_img/normal/GTX101662/GTX101662_44622_20220624_ICC_IF_22062919_735.webp)